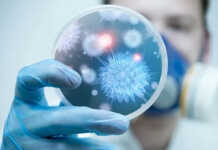

“როგორ უხდება ახალი ვარცხნილობა” – ნახეთ ხვიჩა კვარაცხელიას ახალი იმიჯი
საქართველოს ნაკრებისა და “ნაპოლის” ვარსკვლავს, ხვიჩა კვარაცხელიას ახალი ვარცხნილობა აქვს.
ფოტოები სოციალურ მედიაში ვრცელდება.
წყარო: lelo.ge
BBC კეზერაშვილის თაღლითურ სქემას ამხელს
BBC-მ კეზერაშვილის ლონდონის 18 მილიონი ფუნტის ღირებულების სასახლეს მიაკვლია. ე.წ. ქოლცენტრების საქმეზე BBC-მ საგამოძიებო სიუჟეტი მოამზადა.
ჟურნალისტური გამოძიების ცნობით, ჯგუფ „მილტონის“ კომპანიებთან კავშირების მოკვლევის დროს 5...
უკრაინა თავად იღებს გადაწყვეტილებებს კონტრშეტევასთან დაკავშირებით – ბლინკენი
ტერიტორიების დეოკუპაციის მიზნით ეფექტური კონტრშეტევითი ოპერაციების ჩატარების შესახებ გადაწყვეტილებებს დამოუკიდებლად იღებს უკრაინის სამხედრო ხელმძღვანელობა, - ამის შესახებ აშშ-ის სახელმწიფო მდივანმა ენტონი ბლინკენმა განაცხადა.
მისი თქმით,...
უკრაინა კანადისგან ბირთვულ საწვავს შეისყიდის
უკრაინა ატომურ ელექტროსადგურებში გამოსაყენებლად ბირთვული საწვავის შესყიდვაზე კანადურ კომპანია „კამეკოს“ შეუთანხმდა.
კანადური კომპანია უკრაინას ბირთვული საჭიროებების დასაკმაყოფილებლად ურანს 2035 წლამდე მიაწვდის.
გადაწყვეტილება მიმდინარე წლის დასაწყისში მხარეებს...
ერთადერთი ევროპული ქვეყანა, რომელიც სუვერენიტეტს ინარჩუნებს, უნგრეთია, სწორედ ამიტომაა, რომ უნგრეთის ხელისუფლება, ამერიკელ და...
ფილოსოფოსი ზაზა შათირიშვილი სოციალურ ქსელში მორიგ წერილს აქვეყნებს:
„მოვლენები, რომლებიც „კრედიტ სუისის“ წინააღმდეგ ბიძინა ივანიშვილის დავის გარშემო ვითარდება, კვლავაც გაოცებას იწვევს. სისტემატურად ვიღებთ ახალ მტკიცებულებებს...
რუსეთში ახალი ჰასეკის ვირუსი აღმოაჩინეს
რუსეთში ახალი ჰასეკის ვირუსი აღმოაჩინეს, რომელიც ტკიპების ნაკბენით გადადის, - ამის შესახებ ინფორმაციას რუსული მედია ავრცელებს.
„ჩვენ გავარკვიეთ, რომ ახალი ჰასეკის ვირუსი ადამიანზე გადადის ტკიპიდან და არსებობს...
რა გახდა ბესო მეგრელიშვილის გარდაცვალების მიზეზი
"ჩვენი თეატრისთვის 11 აპრილი მძიმე დღეა. დღეს ეს შემზარავი ამბავი მოხდა, მოულოდნელად ბესო მეგრელიშვილი დავკარგეთ და... ჩვენი მსახიობის, კოტე თოლორდავას გარდაცვალებიდან 8 წელი გავიდა..."...
ქართულ დიასპორაში ეროვნული იდენტობის, ენისა და საქართველოს შესახებ ცოდნის შენარჩუნება სახელმწიფოს ფუნდამენტური ფუნქციაა –...
დიასპორისა და კავკასიის საკითხთა კომიტეტის თავმჯდომარე ბექა ოდიშარია განათლებისა და მეცნიერების სამინისტროს საერთაშორისო ურთიერთობებისა და სტრატეგიული განვითარების დეპარტამენტის უფროს კახა ხანდოლიშვილს და ამავე დეპარტამენტის...
ვოლსკი რადიკალურ ოპოზიციაზე: ფაქტია, რომ ახალგაზრდებთან მათი ნებისმიერი შეკრება ორიენტირებულია აგრესიული აქციების გამართვის ორგანიზებისკენ
პოლიტიკოსებს მეტი პასუხისმგებლობა მართებთ ქვეყნის წინაშე და ფაქტია, რომ მათი ნებისმიერი შეკრება, ურთიერთობები ახალგაზრდებთან სწორედაც რომ ორიენტირებულია აგრესიული აქციების გამართვის ორგანიზებისაკენ და აბსოლუტურად...
“მე კალაძის დამცავად არ გამოვდგები მაგრამ რატომ იკლავს თავს მაგათ გამო ვერ ვხვდები“ –...
ჟურნალისტი მანანა მანჯგალაძე სოციალურ ქსელში სტატუსს აქვეყნებს და წერს:
„ე.ი მე ხომ მიყვარს დაკვირვება და დავაკვირდი, ქოცები რომლებიც ცდილობენ რომ ვითომ კრიტიკულები იყვნენ, ვითომ მაინც...
APLICATIONS
„რატომ ვარ ახლა უფრო იმედიანად, ვიდრე როდისმე 2012 წლის შემდეგ“ –...
საქართველოს ყოფილმა პრეზიდენტმა, მიხეილ სააკაშვილმა, რუსთავის ციხიდან წერილი გამოაგზავნა, რომლის აუდიო ვერსია „TV პირველის“ ეთერში გასაჯაროვდა.
სააკაშვილი წერილში საუბრობს, თუ რატომ არის ახლა უფრო იმედიანად,...